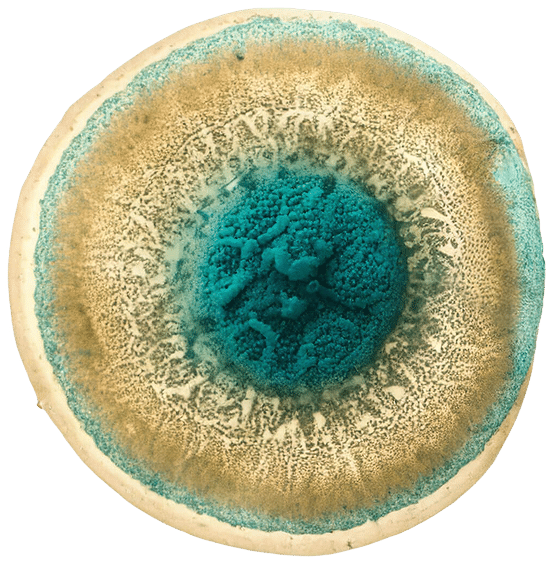

Clinical Evidence – Dezawa MuseCells® & MuseExosomes®
Selected human and preclinical studies illustrating how the Dezawa Muse platform has been investigated across multiple organs and disease areas.
How to Read This Page
This page summarises selected peer-reviewed studies of Muse cells (including Dezawa MuseCells® products and closely related platforms) to give healthcare professionals an at- a-glance overview. Most studies are early phase and focused on safety and feasibility; they should not be interpreted as proof of cure or as definitive efficacy for any indication.
Neurology & CNS
• Randomized, placebo-controlled trial of CL2020 (allogeneic Muse cell-based product) in subacute ischemic stroke – demonstrating acceptable safety and a favourable trend in functional recovery (mRS, NIHSS, Barthel Index) at 12 weeks.
• Phase 2 study of a Muse cell-based product in amyotrophic lateral sclerosis (ALS) – evaluating safety and exploratory effects on functional decline.
• Safety and tolerability study of Muse cells in neonatal hypoxic-ischemic encephalopathy (HIE) alongside therapeutic hypothermia – assessing feasibility of IV infusion in this fragile population.
• Open-label trial of IV Muse cells in subacute cervical traumatic spinal cord injury- showing feasibility, safety and signals of improvement in ASIA scores in some patients.
• Phase 2 study of a Muse cell-based product in amyotrophic lateral sclerosis (ALS) – evaluating safety and exploratory effects on functional decline.
• Safety and tolerability study of Muse cells in neonatal hypoxic-ischemic encephalopathy (HIE) alongside therapeutic hypothermia – assessing feasibility of IV infusion in this fragile population.
• Open-label trial of IV Muse cells in subacute cervical traumatic spinal cord injury- showing feasibility, safety and signals of improvement in ASIA scores in some patients.
Cardiology
First-in-human clinical trial of human Muse cell-based product in acute myocardial infarction (AMI) – evaluating safety, left ventricular function and infarct size over follow-up. Results suggested feasibility and potential benefit, warranting larger trials.
Kidney, Liver & Organ Fibrosis
• Adriamycin nephropathy (FSGS model): systemically administered human Muse cells reduced proteinuria, glomerular sclerosis and podocyte loss, improving renal function versus controls.
• Mouse model of chronic liver fibrosis: Muse cell transplantation led to integration within liver tissue, reduction in fibrosis, and improved liver enzyme profiles.
• Large-animal (e.g., minipig) hepatic fibrosis model: Muse cells contributed to improved histology and liver function, supporting translation to human chronic liver disease settings.
• Mouse model of chronic liver fibrosis: Muse cell transplantation led to integration within liver tissue, reduction in fibrosis, and improved liver enzyme profiles.
• Large-animal (e.g., minipig) hepatic fibrosis model: Muse cells contributed to improved histology and liver function, supporting translation to human chronic liver disease settings.
Musculoskeletal & Skin
Osteochondral repair model in rats: multilineage-differentiating stress-enduring cells
supported cartilage and subchondral bone regeneration, with improved histological scores and joint surface integrity compared with controls.
Additional case series and early experiences in severe skin disorders such as dystrophic epidermolysis bullosa (DEB) suggest potential for structural repair and symptom improvement, though data remain limited.
supported cartilage and subchondral bone regeneration, with improved histological scores and joint surface integrity compared with controls.
Additional case series and early experiences in severe skin disorders such as dystrophic epidermolysis bullosa (DEB) suggest potential for structural repair and symptom improvement, though data remain limited.
Foundational Biology & Safety Reviews
• Longevity and healthy ageing review: comprehensive summary of Muse cell-based regenerative effects across organ systems and discussion of their role in multi-organ healthspan strategies.
• Human adipose tissue Muse discovery paper: identification of a unique SSEA-3+ population with pluripotent-like capacity and nontumorigenic, low-telomerase profile.
• Safety-focused review of Muse cells: aggregation of in vivo models showing functional improvement across organs with no teratoma formation or malignant transformation during follow-up.
• Human adipose tissue Muse discovery paper: identification of a unique SSEA-3+ population with pluripotent-like capacity and nontumorigenic, low-telomerase profile.
• Safety-focused review of Muse cells: aggregation of in vivo models showing functional improvement across organs with no teratoma formation or malignant transformation during follow-up.
Overall Themes & Limitations
Across these studies, several themes emerge: multi-organ regenerative potential, homing to sites of injury, structural integration, and a non-tumorigenic safety profile within current follow-up periods. However, most clinical trials to date are early phase, with limited sample sizes and follow-up durations. Larger randomized trials and long-term registries are needed before broad guideline-level recommendations can be made.